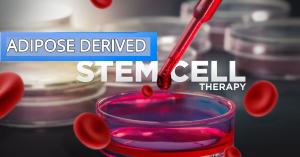

Adipose Derived Stem Cell Therapy Market Poised to Expand at a Robust Pace Over 2028 | BioRestorative Therapies, Inc
Adipose derived stem cells (ADSCs) are stem cells derived from adipocytes, and can differentiate into variety of cell types.
SEATTLE, WASHINGTON, UNITED STATES, February 22, 2022 /EINPresswire.com/ -- Coherent Market Insights has announced new analysis on Adipose Derived Stem Cell Therapy Market Status 2022-2028 which has been prepared based on an in-depth Market analysis with inputs from industry experts and top vendors in the business. The report covers the Market landscape and its development prospects over the coming years. The report also contains a discussion of the key vendors operating in this Market.
The Market analysis report speaks about the growth rate of Adipose Derived Stem Cell Therapy Market till 2028 manufacturing process, key factors driving this Market with sales, revenue, and price analysis of top manufacturers of Market, distributors, traders and dealers of Adipose Derived Stem Cell Therapy Market.
Request Here PDF Brochure Of This Report @ https://www.coherentmarketinsights.com/insight/request-pdf/2357
Adipose Derived Stem Cell Therapy Market study covers Market space, opportunities and threats faced by the vendors in the Adipose Derived Stem Cell Therapy Market, opportunities, Market risk and Market overview of the Market. The process is analysed thoroughly with respect three points, viz. raw material and equipment suppliers, various manufacturing associated costs (material cost, labour cost, etc.) and the actual process.
Adipose Derived Stem Cell Therapy Market reports cover complete modest view with the Market stake and company profiles of the important contestants working in the worldwide Market. Also it offers a summary of product specification, production analysis, technology, product type, considering key features such as gross, gross margin, revenue & cost structure. The report helps the user to strengthen decisive power to plan their strategic moves to launch or expand their businesses by offering them a clear picture of this Market.
If you are involved in the Adipose Derived Stem Cell Therapy Market or intend to be, then this study will provide you comprehensive outlook. It’s vital you keep your Market knowledge up to date segmented by major players. If you have a different set of players/manufacturers according to geography or needs regional or country segmented reports we can provide customization according to your requirement.
Major Players Are: BioRestorative Therapies, Inc., Celltex Therapeutics Corporation, Antria, Inc., Cytori Therapeutics Inc., Intrexon Corporation, Mesoblast Ltd., iXCells Biotechnologies, Pluristem Therapeutics, Inc., Thermo Fisher Scientific, Inc., Tissue Genesis, Inc., Cyagen US Inc., Celprogen, Inc., and Lonza Group, among others.
Major Point cover in this Adipose Derived Stem Cell Therapy Market report are: –
Who are Opportunities, Risk and Driving Force of Adipose Derived Stem Cell Therapy? Knows Upstream Raw Materials Sourcing and Downstream Buyers
Who are the key manufacturers in space? Business Overview by Type, Applications, Gross Margin and Market Share
What are the opportunities and threats faced by the vendors in the Adipose Derived Stem Cell Therapy Market?
What will the Market growth rate, Overview and Analysis by Type of Adipose Derived Stem Cell Therapy in 2028?
What are the key factors driving, Analysis by Applications and Countries industry?
What is Dynamics, This Overview Includes Analysis of Scope and price analysis of top Manufacturers Profiles?
Reasons to buy this Adipose Derived Stem Cell Therapy Market Report
Save time carrying out entry-level research by identifying the size, growth, and leading players in the emerging Adipose Derived Stem Cell Therapy Market
Use the Five Forces analysis to determine the competitive intensity and therefore attractiveness of the emerging Adipose Derived Stem Cell Therapy Market
Leading company profiles reveal details of key Adipose Derived Stem Cell Therapy Market players emerging five operations and financial performance
Add weight to presentations and pitches by understanding the future growth prospects of the emerging Adipose Derived Stem Cell Therapy Market with five year historical forecasts
Compares data from North America, South America, Asia Pacific Europe and Middle East Africa, alongside individual chapters on each region
The next part also sheds light on the gap between supply and consumption. Apart from the mentioned information, growth rate of Adipose Derived Stem Cell Therapy Market in 2028 is also explained. Additionally, type wise and application wise consumption tables and figures of Adipose Derived Stem Cell Therapy Market are also given.
Click Here To Get Sample Copy @ https://www.coherentmarketinsights.com/insight/request-sample/2357
Points cover in Adipose Derived Stem Cell Therapy Market Research Report:
Chapter 1: Overview of Adipose Derived Stem Cell Therapy Market (2022-2028)
• Definition
• Specifications
• Classification
• Applications
• Regions
Chapter 2: Market Competition by Players/Suppliers 2022 and 2028
• Manufacturing Cost Structure
• Raw Material and Suppliers
• Manufacturing Process
• Industry Chain Structure
Chapter 3: Sales (Volume) and Revenue (Value) by Region (2022-2028)
• Sales
• Revenue and Market share
Chapter 4, 5 and 6: Adipose Derived Stem Cell Therapy Market by Type, Application & Players/Suppliers Profiles (2022-2028)
• Market Share by Type & Application
• Growth Rate by Type & Application
• Drivers and Opportunities
• Company Basic Information
Chapter 7, 8 and 9: Adipose Derived Stem Cell Therapy Manufacturing Cost, Sourcing & Marketing Strategy Analysis
• Key Raw Materials Analysis
• Upstream Raw Materials Sourcing
• Marketing Channel
Chapter 10 and 11: Adipose Derived Stem Cell Therapy Market Effect Factors Analysis and Market Size (Value and Volume) Forecast (2022-2028)
• Technology Progress/Risk
• Sales Volume, Revenue Forecast (by Type, Application & Region)
Chapter 12, 13, 14 and 15: Adipose Derived Stem Cell Therapy Market Research Findings and Conclusion, appendix and data source
• Methodology/Research Approach
• Data Source (Secondary Sources & Primary Sources)
• Market Size Estimation
Buy This Research Study Report For Quick Access with Flat USD 2000 Off @ https://www.coherentmarketinsights.com/promo/buynow/2357
About Coherent Market Insights
Coherent Market Insights is a global market intelligence and consulting organization that provides syndicated research reports, customized research reports, and consulting services. We are known for our actionable insights and authentic reports in various domains including aerospace and defense, agriculture, food and beverages, automotive, chemicals and materials, and virtually all domains and an exhaustive list of sub-domains under the sun. We create value for clients through our highly reliable and accurate reports. We are also committed in playing a leading role in offering insights in various sectors post-COVID-19 and continue to deliver measurable, sustainable results for our clients.
Mr. Shah
Coherent Market Insights Pvt. Ltd.
+1 206-701-6702
email us here
Visit us on social media:
Facebook
Twitter
LinkedIn
Other
Legal Disclaimer:
EIN Presswire provides this news content "as is" without warranty of any kind. We do not accept any responsibility or liability for the accuracy, content, images, videos, licenses, completeness, legality, or reliability of the information contained in this article. If you have any complaints or copyright issues related to this article, kindly contact the author above.